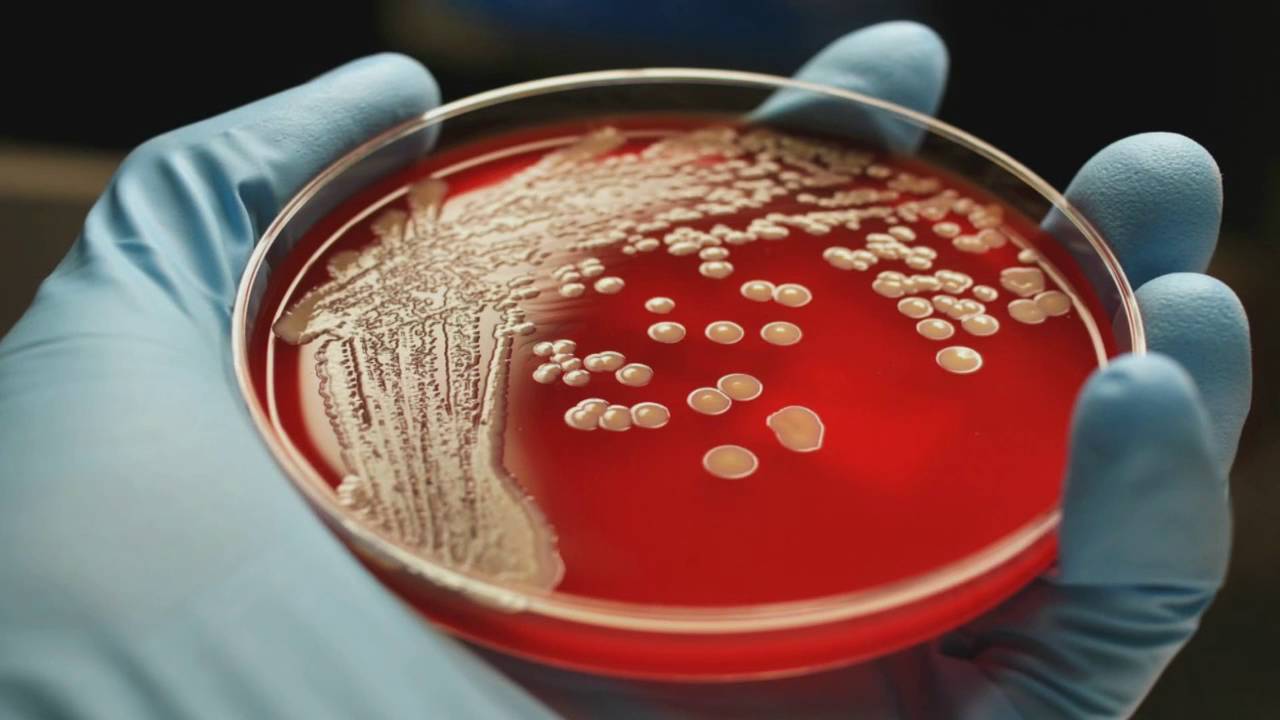

ارتفع عدد الضحايا لـ7.. وفيات المكورات العنقودية تنذر بالخطر
دق مسعفون ناقوس الخطر بشأن قدرة هيئة الخدمات الصحية الوطنية في بريطانيا، على التعامل مع المعدلات المتزايدة لبكتيريا المكورات العنقودية "آي"، بعد تقارير تفيد بأن طفلا سابعا يبلغ من العمر 12 عاما من لندن توفي بعد إصابته بالعدوى.
حيث أفيد، السبت، أن تلميذا يبلغ من العمر 12 عاما من مدرسة في جنوب لندن توفي بعد إصابته بالعدوى، مما سيرفع إجمالي عدد الوفيات إلى سبعة.
وأكدت وكالة الأمن الصحي في المملكة المتحدة، الجمعة، أن ستة أطفال دون سن العاشرة لقوا حتفهم بعد إصابتهم بعدوى بكتيرية منذ سبتمبر، حيث أصدرت تنبيها نادرا استجابة لارتفاع الحالات في جميع أنحاء البلاد.
الأعراض وكيفية الانتشار
بحسب المستشار في هيئة خدمات الصحة والخدمات الإنسانية بالمملكة المتحدة ييمي تشاو، فإن أعراض الإصابة ببكتيريا المكورات العنقودية "أي"، يمكن أن تكون التهابا في الحلق وحمى والتهابات الجلد الطفيفة، ويمكن علاجها بدورة كاملة من المضادات الحيوية.
بيّن تشاو أنه "في حالات نادرة، يمكن أن تتسبب البكتيريا بأعراض قوية وخطيرة مثل ارتفاع في درجة الحرارة وآلام شديدة في العضلات وقيء أو إسهال، وعندها يجب طلب المساعدة العاجلة".
عن طرق انتشار البكتيريا، قال تشاو إن ذلك يتم من خلال السعال والعطس وملامسة الجلد للجلد.
حذر تشاو من أن الأشخاص الذين تزيد أعمارهم عن 65 عاما، أو أولئك المصابين بفيروس نقص المناعة "الإيدز"، أو الذين يستخدمون المنشطات، أو الذين يعانون من مرض السكري أو أمراض القلب أو السرطان هم الأكثر عرضة للإصابة بالعدوى.
المصدر: سكاي نيوز